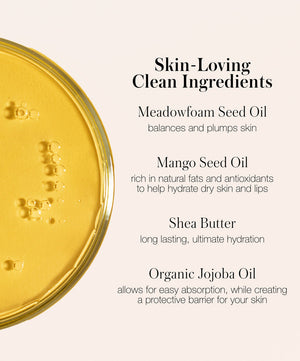
RMS Beauty Go Nude Lip Pencil

Define, enhance, and protect your lips with nourishing pigment.
A richly pigmented, longwearing, skin-caring creamy lip pencil. Expertly formulated to complement an inclusive range of nude shades.
With its own sharpener and brush for flawless precision, it glides on easily to naturally define lips, create fullness, and help keep lipstick from feathering or bleeding. It’s easy to apply, goes on perfectly and stays in place. Formulated with a blend of oils and butters, it conditions and softens lips without settling into fine lines.
Draw a line around the lips with the pencil tip. To enhance your lip size for more impact, draw slightly outside your natural lip line. Blend with the brush to soften the line, or fill in and use as an all over lipcolor. Finish with lip color or gloss.
Go Nude Lip Pencil includes RMS pencil sharpener.
Midnight Nude: Hydrogenated Jojoba Oil, Mica, Caprylic/Capric Triglyceride, Limnanthes Alba (Meadowfoam) Seed Oil, Mangifera Indica (Mango) Seed Oil, Euphorbia Cerifera (Candelilla) Wax/Candelilla Cera/Cire decandelilla, Silica, Butyrospermum Parkii (Shea) Butter, Macadamia Integrifolia Seed Oil, Copernicia Cerifera (Carnauba) Wax/Cera Carnauba/Cire de carnauba, *Simmondsia Chinensis (Jojoba) Seed Oil, Tocopherol(non-GMO), Helianthus Annuus (Sunflower) Seed Oil, Ascorbyl Palmitate, Iron Oxides (CI 77491, CI 77492, CI77499), Titanium Dioxide (CI 77891).
Daytime Nude, Morning Dew, Sunset Nude: Hydrogenated Jojoba Oil, Limnanthes Alba (Meadowfoam) SeedOil, Caprylic/Capric Triglyceride, Mica, Mangifera Indica (Mango) Seed Oil, Euphorbia Cerifera (Candelilla) Wax/Candelilla Cera/Cire de candelilla, Silica, Butyrospermum Parkii (Shea) Butter, Copernicia Cerifera (Carnauba) Wax/Cera Carnauba/Cire de carnauba, *Simmondsia Chinensis (Jojoba) Seed Oil, Tocopherol(non-GMO), Helianthus Annuus (Sunflower) Seed Oil, Ascorbyl Palmitate, Titanium Dioxide (CI 77891), IronOxides (CI 77491, CI 77492, CI 77499), May Contain (+/-): Manganese Violet (CI 77742), Yellow 5 Lake (CI19140), Red 6 (CI 15850).
Nighttime Nude: Hydrogenated Jojoba Oil, Caprylic/Capric Triglyceride, Mica, Limnanthes Alba(Meadowfoam) Seed Oil, Mangifera Indica (Mango) Seed Oil, Euphorbia Cerifera (Candelilla) Wax/CandelillaCera/Cire de candelilla, Butyrospermum Parkii (Shea) Butter, Macadamia Integrifolia Seed Oil, CoperniciaCerifera (Carnauba) Wax/Cera Carnauba/Cire de carnauba, *Simmondsia Chinensis (Jojoba) Seed Oil,Tocopherol (non-GMO), Silica, Helianthus Annuus (Sunflower) Seed Oil, Ascorbyl Palmitate, Titanium Dioxide(CI 77891), Iron Oxides (CI 77491, CI 77492, CI 77499).
Sunrise Nude: Hydrogenated Jojoba Oil, Caprylic/Capric Triglyceride, Limnanthes Alba (Meadowfoam) SeedOil, Mica, Mangifera Indica (Mango) Seed Oil, Euphorbia Cerifera (Candelilla) Wax/Candelilla Cera/Cire decandelilla, Silica, Butyrospermum Parkii (Shea) Butter, Macadamia Integrifolia Seed Oil, Copernicia Cerifera(Carnauba) Wax/Cera Carnauba/Cire de carnauba, *Simmondsia Chinensis (Jojoba) Seed Oil, Tocopherol(non-GMO), Helianthus Annuus (Sunflower) Seed Oil, Ascorbyl Palmitate, Titanium Dioxide (CI 77891), IronOxides (CI 77492, CI 77499), May Contain (+/-) Iron Oxides (CI 77491), Manganese Violet (CI 77742), Red 6(CI 15850), Red 7 (CI 15850), Yellow 6 Lake (CI 15985).
Pavla Red: Hydrogenated Jojoba Oil, Caprylic/Capric Triglyceride, Limnanthes Alba (Meadowfoam) Seed Oil, Mica, Mangifera Indica (Mango) Seed Oil, Euphorbia Cerifera (Candelilla) Wax/Candelilla Cera/Cire decandelilla, Silica, Butyrospermum Parkii (Shea) Butter, Macadamia Integrifolia Seed Oil, Copernicia Cerifera (Carnauba) Wax/Cera Carnauba/Cire de carnauba, *Simmondsia Chinensis (Jojoba) Seed Oil, Tocopherol (non-GMO), Helianthus Annuus (Sunflower) Seed Oil, Ascorbyl Palmitate, Titanium Dioxide (CI 77891), Iron Oxides (CI 77492, CI 77499), May Contain (+/-) Iron Oxides (CI 77491), Manganese Violet (CI 77742), Red 6 (CI 15850), Red 7 (CI 15850), Yellow 6 Lake (CI 15985).
*Organic